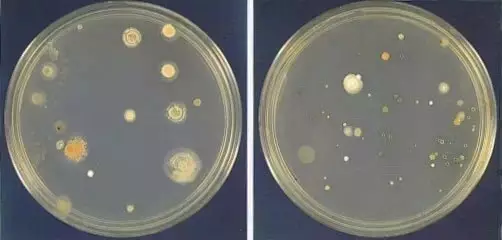
4

5617次
2025-04-16實驗室和細胞工廠在細胞培養過程中,支原體污染一直是困擾我們的疑難雜癥。據統計,常規細胞培養中支原體污染一般能達到30%,甚至更多,嚴重干擾了實驗結果的可信度。因此,定期進行支原體檢測和去除,確保細胞培養體系內無支原體存在才能獲得準確有效的實驗數據。
支原體是什么?
支原體是1898年Nocard等發現的一種類似細菌但不具有細胞壁的原核微生物,能在無生命的人工培養基上生長繁殖,直徑50-300nm,能通過細菌濾器。支原體在過去曾稱之為類胸膜肺炎微生物,1967年正式命名為支原體。
支原體又稱霉形體,為目前發現的較小較簡單的原核生物,基因數量為480。支原體細胞中唯一可見的細胞器是核糖體。支原體通常依附在細胞膜表面,結構也比較簡單,多數呈球形,沒有剛性的細胞壁,因此很多抗生素對其不起作用。只有三層結構的細胞膜,故具有較大的可變性。實驗室常見的種類有:口腔支原體、精氨酸支原體、豬鼻支原體、發酵支原體、人型支原體、唾液支原體、肺支原體和梨支原體等。

支原體污染的原因是什么?
支原體污染一直是困擾實驗室細胞培養的難題,其來源主要是有以下幾個方面:
1. 細胞之間交叉污染;
2. 工作環境或實驗器材的污染;
3. 實驗者無菌操作不佳;
4. 培養基或其他試劑污染;
5. 制備細胞的原始組織或器官的污染;
支原體污染的危害是什么?
細胞培養中的污染類型很多,其中細菌和真菌造成的污染相對比較容易檢測、預防和去除,然而支原體造成的污染很難察覺,即使生長密度高達107~109CFU/mL也很難有污染跡象(渾濁、pH變化等)。支原體污染后會導致細胞生長變慢,狀態變差,不會馬上使細胞致死,但會影響細胞內的各種參數,如改變細胞膜抗原性,改變細胞新陳代謝,干擾核酸的合成,改變DNA轉染效率導致染色體畸變等。

支原體檢測方法有哪些?
檢測支原體的方法一般有分離培養法、指示細胞培養法(DNA染色法)、化學發光法(特異酶學檢測)、ELISA法、PCR法。
1. 支原體分離培養法
支原體分離培養法是檢測支原體的金標方法,其檢測精確度較高。此方法非常經典,在世界范圍內得到廣泛認可,《中國藥典》2020版第四部分3301和歐洲藥典第六版2.6.7部分均有記載。這種方法是從可疑的細胞培養體系中取樣,并接種到培養基靈敏度檢查合格的支原體瓊脂培養基上,如果樣本中含有支原體,它們就會在支原體瓊脂基上生長,較終形成明顯可見的特征性菌落。
由于分離培養法基本不會出現假陰性結果,因此也被譽為支原體檢測金標準。不過分離培養法也存在兩個弊端,一是檢測時間太長,支原體要在培養基上長出明顯克隆需要4周左右,且操作也較復雜;二是盡管可以檢測絕大多數的支原體種類,但也存在個別無法檢測的情況,例如支原體M. hyorhinis。
2. 指示細胞培養法(DNA染色法)
指示細胞培養法是指將供試品接種于指示細胞(一般選擇細胞質區域較大無污染的Vero細胞或經國家專業鑒定機構認可的其它細胞)中培養后,用特異熒光染料(如Hoechst染料)染色,然后在熒光顯微鏡下觀察。如供試品有支原體污染,就可以在指示細胞表面觀察到熒光斑點或熒光顆粒,與細胞核呈現的更大更亮橢圓形的熒光形成鮮明對比。

指示細胞培養法(DNA染色法)也是《中國藥典》2020版第四部分3301認可的支原體檢測方法,由于供試品要與指示細胞共同培養,因此也需要3~5天的時間。較大的優點就是較為快速,直觀,但是它的靈敏度會比較低,在支原體污染不嚴重時容易得到模棱兩可的結果,只有在污染嚴重時才能得到可靠度較高的結果。此外Hoechst染色試劑對人體有害,要注意防護;且固定液含有冰乙酸,有刺激性氣味,需要在通風櫥內進行固定操作;熒光染料都存在淬滅的問題,建議染色后盡量當天完成檢測。
3. 化學發光法(特異酶學檢測)
化學發光法的原理是利用支原體內特有的酶,與提供的底物相互作用,使其中的ADP轉化為ATP,熒光素酶可以利用產生的ATP與熒光素酶底物發生反應,能產生可以被儀器檢測到的光。如果沒有支原體存在,熒光素酶就沒有足夠的ATP去發生反應產生光,儀器檢測到的數值就比較低;如果有支原體存在,就可以使大量的ADP轉化為ATP,供熒光素酶發生反應,產生大量的光,儀器檢測到的數值就比較高。

這種方法的優點是檢測的靈敏度高,速度快,但只能檢測活的支原體。
4. ELISA法
ELISA法也能用于支原體檢測,以ELISA法為基礎的支原體檢測一般使用針對支原體16S rRNA基因的帶標記探針或抗體,也有一些商品化的支原體Elisa試劑盒來檢測培養物中是否含有支原體。

ELISA法是一種很考驗操作者技術的檢測方法,而且很依賴抗體,有一定局限性,無法對沒有抗體或目前找不到抗體的支原體進行檢測,而且稍不留意就容易出現實驗誤差。方法相對復雜,用得也比較少。但是特異性高,時間也比較短,3~5小時就可以觀察結果。
5. PCR法
PCR法也是目前較常用的方法,它的檢測方式主要有凝膠電泳檢測和熒光PCR定量檢測。其原理都是在支原體16S rRNA基因的保守區設計引物,通過檢測支原體DNA來檢測細胞中有無支原體的污染。
在凝膠電泳過程中,支原體DNA會顯示為特異性條帶,以此指示支原體的存在。

在用熒光PCR定量擴增時,觀察圖譜及Ct值可判斷是否有支原體存在。

PCR法的優點是檢測靈敏度高,特異性好,檢測速度快,可在幾個小時內識別細胞培養物中是否有支原體污染。但存在測試過程中污染物易從陽性對照(或其他以前對支原體測試呈陽性的樣品)傳播到未受影響的樣品的風險,從而導致假陽性結果,此外也不能判斷滅活處理后的樣品是否還有活的支原體。
支原體非常頑強,通常用于細胞培養的絕大多數抗生素都對其無效。無懈可擊的細胞培養技術始終是預防支原體感染的較佳方式,另外及時找出受到支原體感染的培養物也很重要,這樣才能在感染擴散前快速采取有效措施。
祝實驗室各位小伙伴都能早日培養出自己心儀的細胞!
掃碼添加史工 掃碼添加嚴工

掃碼添加史工 掃碼添加嚴工
聯系人:史工18928790749、嚴工
聯系電話:19924323595、020-82118202、020-31608627
地址:廣州市黃埔區攬月路3號F棟316(總部)廣州市黃埔區科學城尖塔山路1號(動物中心)



